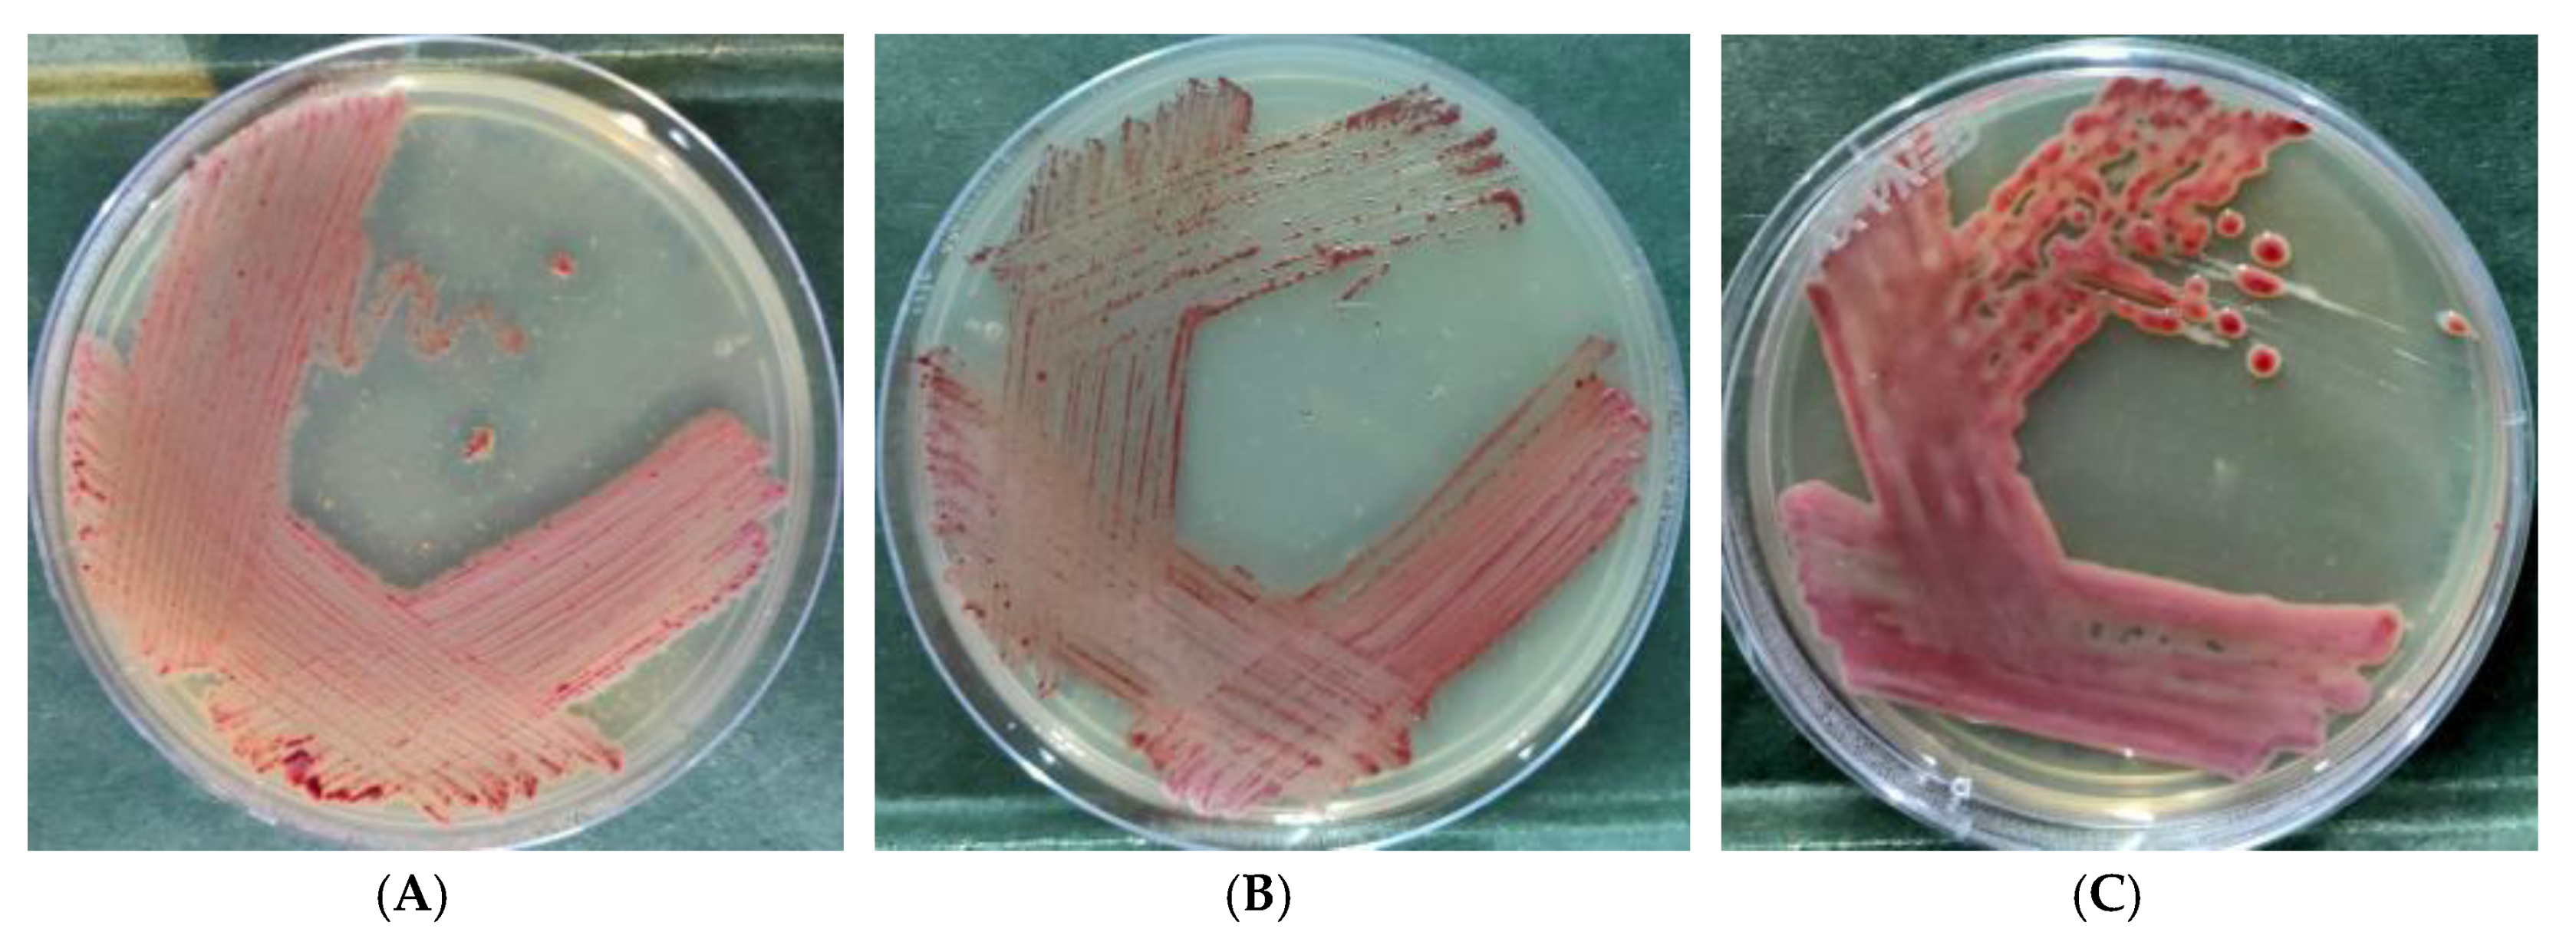
Ijerph 17 04274 g001 Ijerph 17 04274 g001
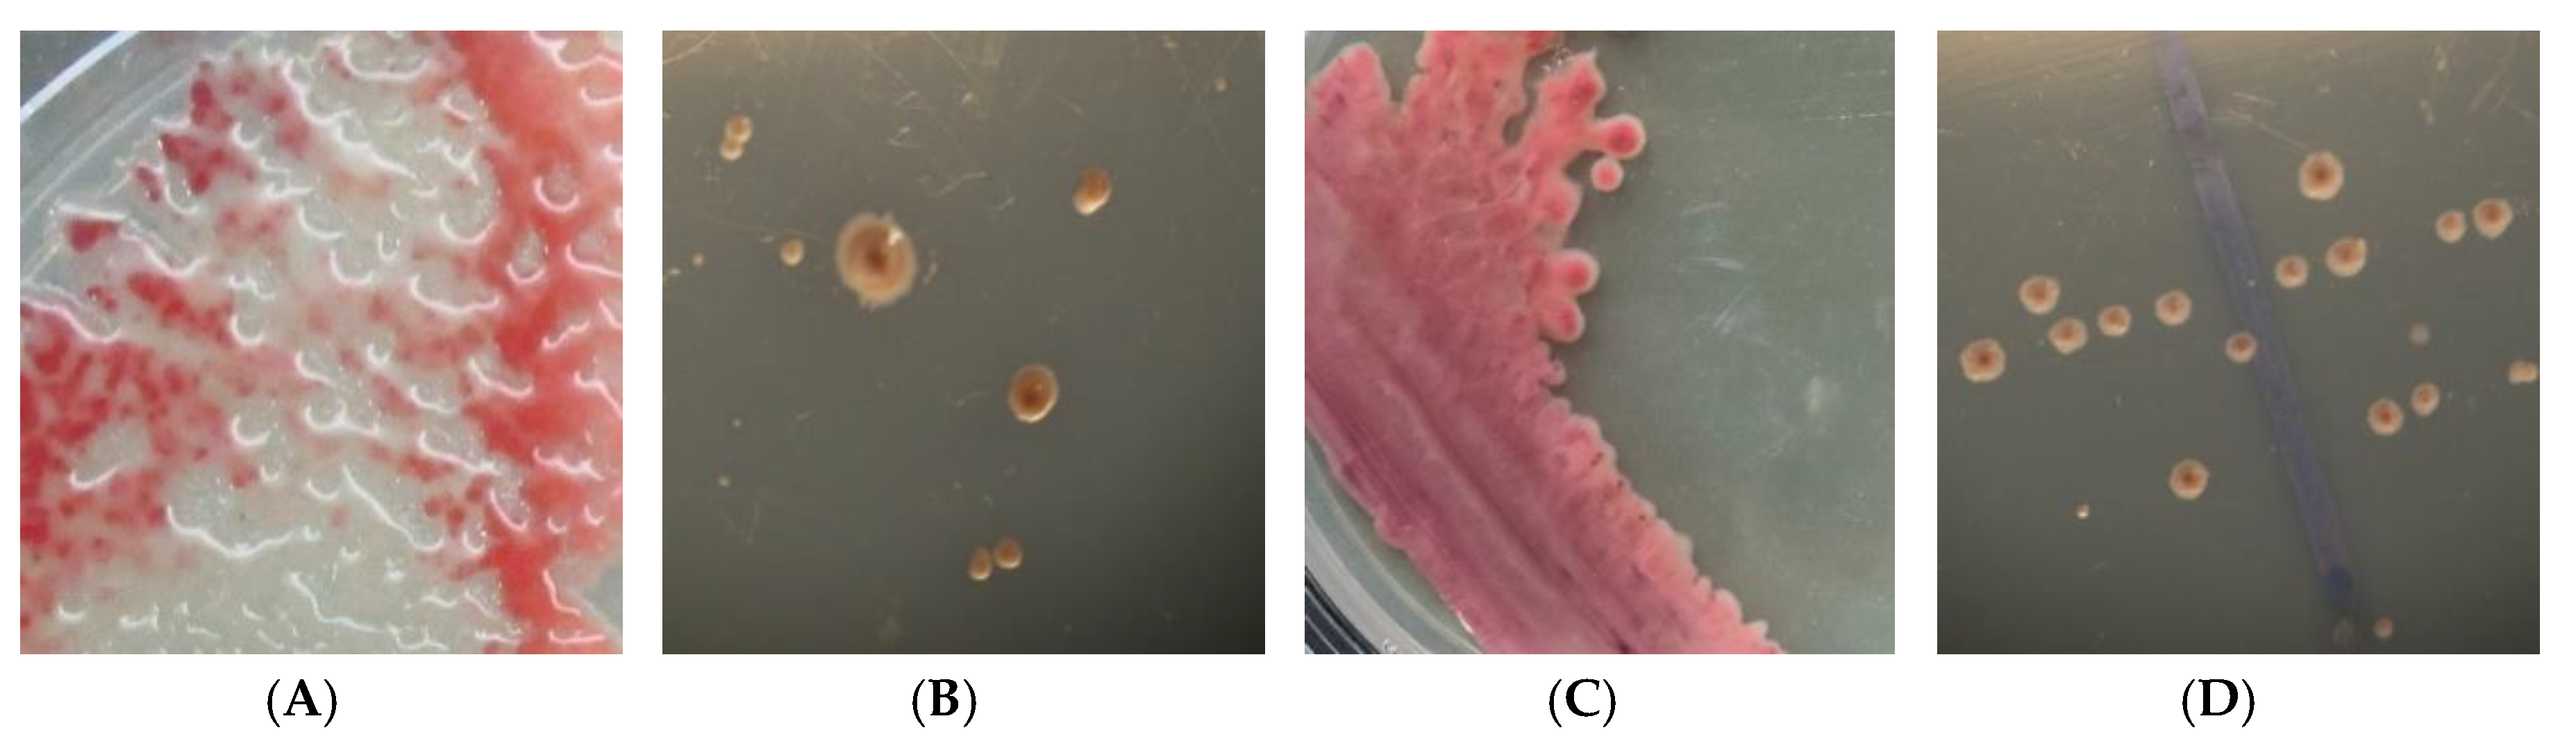
Ijerph 17 04274 g002 Ijerph 17 04274 g002

A Simplified Protocol for Reversing Phenotypic Conversion of Ralstonia solanacearum during Experimentation
Abstract
1. Introduction
2. Material and Methods
2.1. Ralstonia solanacearum Strains
2.2. PC Reversal and Virulence Induction Protocol
2.2.1. Preparation of P. emblica Extract
2.2.2. Preparation of Nutrient Gradient and Inoculation
2.3. Effect of P. emblica Extract and Nutrient Deprivation on PC Reversal
2.3.1. Live–Dead Cell Imaging
2.3.2. Bacteriostatic Effect of Ascorbic Acid Present in P. emblica Extract
2.3.3. Effect on Other Virulence Factors
2.3.4. GFP Tagging of R. solanacearum Strains
2.3.5. In Vivo Confirmation of Virulence
2.3.6. Confocal Scanning Laser Microscopy to Confirm Virulence In Vivo
2.4. Statistical Analysis
3. Results and Discussion
3.1. Reversal of PC Due to P. emblica Extract and Nutrient Deprivation
3.2. Bacteriostatic Effect of P. emblica Extract
3.3. Role of Nutrient Deprivation
3.4. Effect on Other Virulence Factors
3.5. In Vivo Virulence of Converted Fluidal Colonies
4. Conclusions
Supplementary Materials
Author Contributions
Funding
Acknowledgments
Conflicts of Interest
References
- Hayward, A.C. Biology and epidemiology of bacterial wilt caused by Pseudomonas solanacearum. Annu. Rev. Phytopathol. 1991, 29, 65–87. [Google Scholar] [CrossRef] [PubMed]
- Mansfield, J.; Genin, S.; Magori, S.; Citovsky, V.; Sriariyanum, M.; Ronald, P.; Dow, M.A.X.; Verdier, V.; Beer, S.V.; Machado, M.A.; et al. Top 10 plant pathogenic bacteria in molecular plant pathology. Mol. Plant Pathol. 2012, 13, 614–629. [Google Scholar] [CrossRef] [PubMed]
- Dannon, E.A.; Wydra, K. Interaction between silicon amendment, bacterial wilt development and phenotype of Ralstonia solanacearum in tomato genotypes. Physiol. Mol. Plant Pathol. 2004, 64, 233–243. [Google Scholar] [CrossRef]
- Kuroki, T.; Mori, T.; Komatsu, A.; Nakahara, H.; Matsusaki, H.; Matsuzoe, N. Suppression of bacterial wilt in potatoes by non-pathogenic Ralstonia solanacearum using bud pieces and plants grown from bud pieces. Hortic. Res. 2016, 15, 207–212. [Google Scholar] [CrossRef][Green Version]
- Kelman, A.; Hruschka, J. The role of motility and aerotaxis in the selective increase of avirulent bacteria in still broth culture of Pseudomonas solanacearum. J. Gen. Microbiol. 1973, 76, 177–188. [Google Scholar] [CrossRef] [PubMed]
- Brumbley, S.M.; Denny, T.P. Cloning of wild-type Pseudomonas solanacearum phcA, a gene that when mutated alters expression of multiple traits that contribute to virulence. J. Bacteriol. 1999, 172, 5677–5685. [Google Scholar] [CrossRef]
- Kelman, A. One hundred and one years of research on bacterial wilt. In Bacterial Wilt Disease; Springer: Berlin/Heidelberg, Germany, 1998; pp. 1–5. [Google Scholar]
- Schell, M.A. To be or not to be: How Pseudomonas solancearum decides whether or not to express virulence genes. Eur. J. Plant Pathol. 1996, 102, 459–469. [Google Scholar] [CrossRef]
- Zhang, Y.; Wen, T.; Lin, J.; Xie, Z.; Liu, S.; Rao, P. Characterization and identification of Ralstonia solanacearum by ion-exchange chromatography. Chin. J. Chromatogr. 2005, 23, 418–421. [Google Scholar]
- Lin, J.; Ma, C.; Liu, S.; Wu, L.; Rao, P. High speed separation and quantitation of Ralstonia solanacearum of different virulence using high performance ion-exchange chromatography. Chin. J. Chromatogr. 2007, 25, 70–74. [Google Scholar] [CrossRef]
- Kelman, A. The relationship of pathogenicity of Pseudomonas solanacearum to colony appearance in a tetrazolium medium. Phytopathology 1954, 44, 693–695. [Google Scholar]
- Denny, T.P.; Baek, S.R. Genetic evidence that extracellular polysaccharide is a virulence factor. Mol. Plant Microbe Interact. 1991, 4, 198–206. [Google Scholar] [CrossRef]
- Mori, T.; Fujiyoshi, T.; Inada, T.; Matsusaki, H.; Ogawa, K.; Matsuzoe, N. Phenotypic conversion of Ralstonia solanacearum in susceptible and resistant Solanum plants. Environ. Control. Biol. 2011, 49, 165–176. [Google Scholar] [CrossRef]
- Nakahara, H.; Mori, T.; Sadakari, N.; Matsusaki, H.; Matsuzoe, N. Biological control of the bacterial wilt of the tomato ‘micro-tom’ by phenotypic conversion mutants of Ralstonia solanacearum. Environ. Control. Biol. 2016, 54, 139–145. [Google Scholar] [CrossRef]
- Nakahara, H.; Mori, T.; Matsusaki, H.; Matsuzoe, N. Growth inhibition of the Ralstonia solanacearum wild-type strain in a culture filtrate of phenotypic conversion mutant strain. Environ. Control. Biol. 2016, 54, 133–138. [Google Scholar] [CrossRef][Green Version]
- Ogawa, K.; Mori, T.; Matsusaki, H.; Matsuzoe, N. Effect of the colonization of non-pathogenic Ralstonia solanacearum on the suppression of bacterial wilt in eggplant. Hortic. Res. 2012, 11, 399–403. [Google Scholar] [CrossRef][Green Version]
- Schell, M.A. Control of virulence and pathogenicity genes of Ralstonia solanacearum by an elaborate sensory network. Annu. Rev. Phytopathol. 2000, 38, 263–292. [Google Scholar] [CrossRef]
- Pradhanang, P.M.; Momol, M.T.; Olson, S.M.; Jones, J.B. Effects of plant essential oils on Ralstonia solanacearum population density and bacterial wilt incidence in tomato. Plant Dis. 2003, 87, 423–427. [Google Scholar] [CrossRef] [PubMed]
- Sukanya, S.L.; Sudisha, J.; Hariprasad, P.; Niranjana, S.R.; Prakash, H.S.; Fathima, S.K. Antimicrobial activity of leaf extracts of Indian medicinal plants against clinical and phytopathogenic bacteria. Afr. J. Biotechnol. 2009, 8, 6677–6682. [Google Scholar]
- Parveen, K.; Khatkar, B.S. Physico-chemical properties and nutritional composition of aonla (Emblica officinalis) varieties. Int. Food Res. J. 2015, 22, 2358. [Google Scholar]
- Durairaj, K.; Velmurugan, P.; Park, J.H.; Chang, W.S.; Park, Y.J.; Senthilkumar, P.; Choi, K.M.; Lee, J.H.; Oh, B.T. Potential for plant biocontrol activity of isolated Pseudomonas aeruginosa and Bacillus stratosphericus strains against bacterial pathogens acting through both induced plant resistance and direct antagonism. FEMS Microb. Lett. 2017, 364, 225. [Google Scholar] [CrossRef] [PubMed]
- Meddeb-Mouelhi, F.; Moisan, J.K.; Beauregard, M. A comparison of plate assay methods for detecting extracellular cellulase and xylanase activity. Enzyme Microb. Technol. 2014, 66, 16–19. [Google Scholar] [CrossRef] [PubMed]
- Singh, S.; Singh, U.B.; Trivedi, M.; Sahu, P.K.; Paul, S.; Paul, D.; Saxena, A.K. Seed biopriming with salt-tolerant endophytic Pseudomonas geniculata modulate biochemical responses provides ecological fitness in maize (Zea mays L.) grown in saline sodic soil. Int. J. Environ. Res. Public Health 2020, 17, 253. [Google Scholar] [CrossRef] [PubMed]
- Li, S.; Liu, Y.; Wang, J.; Yang, L.; Zhang, S.; Xu, C.; Ding, W. Soil acidification aggravates the occurrence of bacterial wilt in South China. Front. Microbiol. 2017, 8, 703. [Google Scholar] [CrossRef] [PubMed]
- De Britto, A.J.; Gracelin, D.H.S.; Sebastian, S.R. Antibacterial activity of a few medicinal plants against Xanthomonas campestris and Aeromonas hydrophila. J. Biopestic. 2011, 4, 57. [Google Scholar]
- Tambekar, D.H.; Dahikar, S.B. Antibacterial activity of some Indian Ayurvedic preparations against enteric bacterial pathogens. J. Adv. Pharm. Technol. Res. 2011, 2, 24. [Google Scholar] [CrossRef]
- Goyal, R.K.; Patil, R.T.; Kingsly, A.R.P.; Pradeep, K.H.W. Status of postharvest technology of aonla in India-A review. Am. J. Food Technol. 2008, 3, 13–23. [Google Scholar] [CrossRef][Green Version]
- Poussier, S.; Thoquet, P.; Trigalet-Demery, D.; Barthet, S.; Meyer, D.; Arlat, M.; Trigalet, A. Host plant-dependent phenotypic reversion of Ralstonia solanacearum from non-pathogenic to pathogenic forms via alterations in the phcA gene. Mol. Microbiol. 2003, 49, 991–1003. [Google Scholar] [CrossRef]
- Yang, L.; Wu, L.; Yao, X.; Zhao, S.; Wang, J.; Li, S.; Ding, W. Hydroxycoumarins: New, effective plant-derived compounds reduce Ralstonia pseudosolanacearum populations and control tobacco bacterial wilt. Microbiol. Res. 2018, 215, 15–21. [Google Scholar] [CrossRef]
- Van Elsas, J.D.; Kastelein, P.; de Vries, P.M.; van Overbeek, L.S. Effects of ecological factors on the survival and physiology of Ralstonia solanacearum biovar 2 in agricultural drainage water. Can. J. Microbiol. 2001, 47, 842–854. [Google Scholar] [CrossRef]
- Peeters, N.; Guidot, A.; Vailleau, F.; Valls, M. Ralstonia solanacearum, a widespread bacterial plant pathogen in the post genomic era. Mol. Plant Pathol. 2013, 14, 651–662. [Google Scholar] [CrossRef]
- Andargie, M.; Li, L.; Feng, A.; Zhu, X.; Li, J. Development of a GFP-expressing Ustilaginoidea virens strain to study fungal invasion and colonization in rice spikelets. S. Afr. J. Bot. 2015, 97, 16–24. [Google Scholar] [CrossRef]
- Chalupowicz, L.; Zellermann, E.M.; Fluegel, M.; Dror, O.; Eichenlaub, R.; Gartemann, K.H.; Savidor, A.; Sessa, G.; Iraki, N.; Barash, I.; et al. Colonization and movement of GFP-labeled Clavibacter michiganensis subsp. michiganensis during tomato infection. J. Phytopathol. 2012, 102, 23–31. [Google Scholar]

| SN. Colony Morphology (before Experiment) | Colony Morphology around Wells Containing Phyllanthus emblica Extract | ||||
|---|---|---|---|---|---|
| Full-Strength KMTTC | 1/50 Strength KMTTC | ||||
| 24 h | 72 h | 24 h | 72 h | ||
| 1 | Butyrous (NAIMCC-B-01630) | NF | NF | NG | F |
| 2 | Butyrous (TB-01838) | NF | NF | NG | F |
| 3 | Non-fluidal (NAIMCC-B-01630) | NF | F | NG | F |
| 4 | Fluidal (NAIMCC-B-01630) | F | F | NG | F |
| S. No. | Physiological State of R. solanacearum | Mortality (%) | |
|---|---|---|---|
| Susceptible Cultivar (Pusa Ruby) | Resistant Cultivar (Arka Rakshak) | ||
| 1 | Control | 0.00 d | 0.00 c |
| 2 | Fluidal | 77.74 a | 24.30 a |
| 3 | Non-fluidal | 11.11 c | 1.39 c |
| 4 | Converted fluidal | 63.89 b | 14.58 b |
© 2020 by the authors. Licensee MDPI, Basel, Switzerland. This article is an open access article distributed under the terms and conditions of the Creative Commons Attribution (CC BY) license (http://creativecommons.org/licenses/by/4.0/).
Share and Cite
Sahu, P.K.; Singh, S.; Gupta, A.; Singh, U.B.; Paul, S.; Paul, D.; Kuppusamy, P.; Singh, H.V.; Saxena, A.K. A Simplified Protocol for Reversing Phenotypic Conversion of Ralstonia solanacearum during Experimentation. Int. J. Environ. Res. Public Health 2020, 17, 4274. https://doi.org/10.3390/ijerph17124274
Sahu PK, Singh S, Gupta A, Singh UB, Paul S, Paul D, Kuppusamy P, Singh HV, Saxena AK. A Simplified Protocol for Reversing Phenotypic Conversion of Ralstonia solanacearum during Experimentation. International Journal of Environmental Research and Public Health. 2020; 17(12):4274. https://doi.org/10.3390/ijerph17124274
Chicago/Turabian StyleSahu, Pramod Kumar, Shailendra Singh, Amrita Gupta, Udai B. Singh, Surinder Paul, Diby Paul, Pandiyan Kuppusamy, Harsh V. Singh, and Anil Kumar Saxena. 2020. "A Simplified Protocol for Reversing Phenotypic Conversion of Ralstonia solanacearum during Experimentation" International Journal of Environmental Research and Public Health 17, no. 12: 4274. https://doi.org/10.3390/ijerph17124274
APA StyleSahu, P. K., Singh, S., Gupta, A., Singh, U. B., Paul, S., Paul, D., Kuppusamy, P., Singh, H. V., & Saxena, A. K. (2020). A Simplified Protocol for Reversing Phenotypic Conversion of Ralstonia solanacearum during Experimentation. International Journal of Environmental Research and Public Health, 17(12), 4274. https://doi.org/10.3390/ijerph17124274

